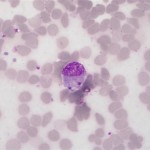

Photogallery
-

-
Albano e Cristina
-

-
Belen
-

-
Hal e Sidra Stone Ph. all’Università di Arezzo
-

-
Medicina Tradizionale e Olistica
-

-
Il Buio dentro la Carne
-

-
L’Uomo Albero
-

-
Cynthia Collu
-

-
Collezionare Manichini
-

-
Allestimento esterno mostra del Canova di Forlì
-

-
Tamara De Lempicka la dormeuse
-

-
I sette chakra principali
-

-
Gaja Cenciarelli ideatrice di Auroralia
-

-
Bellezza a cinque stelle
-

-
Invidia
-

-
Thomas Leoncini
-

-
Arcobaleno
-

-
Victor Hissel
-

-
Bollino Rosso
-

-
Marc Dutroux
-

-
Victor Hissel
-

-
Victor Hissel
-

-
Michael Jackson
-

-
Michael Jackson
-

-
Michael Jackson
-

-
Michael Jackson e padre
-

-
Michael Jackson
-

-
Heiko Bleher
-

-
Heiko Bleher in Australia
-

-
Triops
-

-
Hemigrammus bleheri
-

-
Lepidogalaxias-salamandroides
-

-
Symphysodon-aequifasciatus
-

-
ISBN978-88-901816-2-7
-

-
Amanda Bleher
-

-
toscana stemma chianti classico
-

-
Lisa Tormena e Matteo Lolletti vincitori al Premio Ilaria Alpi
-

-
Ophelia di Odillon Redon
-

-
thomas leoncini
-

-
meditazione
-

-
Perchè non ricordo i sogni
-

-
vignetta umoristica
-

-
foto treno
-

-
Veronica Lario Berlusconi
-

-
Julie e Melissa
-

-
San Francesco
-

-
Amadeus
-

-
melanzana
-

-
Regina Louf
-

-
pesci tatuati
-

-
ciambellette
-

-
Eraldo Baldini e Marzia Mazzavillani a Marina Romea
-

-
thomas leoncini
-

-

-
bauhaus
-

-
Hans hartung studio
-

-
Edoardo Raspelli – Kseniya Zaynak
-

-
Eugene Delacroix
-

-
Gregoraci-Briatore
-

-
Michel Nihoul
-

-
Miracolo vivente – baby
-

-
Gian Maria Aliberti
-

-
Closed eyes di Odillon Redon
-

-
Thomas Leoncini
-

-
Foto Thomas Leoncini
-

-
Odilon Redon Sita
-

-

-
amore materno
-

-
Buon Natale
-

-
bali-lake-bratan-temple
-

-
Diego Dalla Palma
-

-
amore materno
-

-
Swine Flu
-

-
piero marrazzo
-

-
Dicembre
-

-
Alba Parietti per OK la salute
-

-
Al Bano per OK la salute
-

-
OK la salute
-

-
Bimbo
-

-
mani dal crocifisso
-

-
Fulvio Liliana
-

-
Maria Grazia Cucinotta
-

-
ritratto-chieregato
-

-
Natale
-

-
angeli
-

-
Giada Valenti
-

-

-

-
Gullit e Estelle
-

-
Nina Moric
-

-
fidanzato di Brenda
-

-
Lamberto Sposini – La vita in diretta
-

-
Giorgio Sgarra
-

-
Riek van Eijk
-

-
Sarah Jessica Parker
-

-
Alzheimer
-

-
Edward Hopper
-

-

-
Thomas Leoncini
-

-
Sergio Fedriani
-

-
Sergio Fedriani
-

-

-
zeppole natalizie di sorrento
-

-
Laura Dekker
-

-
Chanda Ranga
-

-
Valeria Marini Lato A
-

-
Holi Festival
-

-

-
partner irritanti
-

-
Carlo Ravaioli nel suo atelier
-

-
Francobollo
-

-
Il mio cane alle prese con l’impermeabile
-

-
Il mio cane sembra feroce……ma non lo è affatto !!!
-

-
Il suo migliore travestimento….
-

-

-
Panda
-

-
Cordyceps_ophioglossoides
-

-
dolce_e_gabbana sfilate
-

-
Geert Wilders
-

-
amore e psiche canova
-

-
edgardo-pronto-per-affrontare-la-pioggia
-

-
edgardo versione terrorista
-

-
la passione di edgardo per i biscotti-
-

-
Milly Carlucci – Ballando con le stelle – Paolo Belli
-

-
torture
-

-

-
thomas leoncini
-

-
Antonella Clerici
-

-

-
Panico
-

-

-

-

-
Marion Reiss
-

-
sogni ricorrenti
-

-
mimosa
-

-

-

-
concorso di pittura on line Il cofanetto magico
-

-
modigliani
-

-

-

-

-

-

-

-

-
tamara de lempicka
-

-
foto thomas leoncini
-

-
colomba della pace picasso
-

-
pastiera-napoletana
-

-

-

-
treppy1
-

-

-

-

-
Le Guide semplici della Banca d’Italia
-

-

-
se mi lasci non male
-

-
sogni di compensazione guidare auto decapotabile
-

-

-

-

-

-

-

-

-

-

-

-

-

-

-

-
Loredana Lecciso
-

-
gattino sul ramo di salice
-

-
gatta Luna
-

-
vecchiaia
-

-
Clark Gable e Vivien Leigh
-

-

-
Umberto Brindani
-

-
la casa dei sogni
-

-

-
baba napoletano
-

-
Sogni di conferma
-

-
Roswell Daily Record 9 luglio 1947
-

-
Stelio Montebugnoli (foto di Nicola Allegri)
-

-
Padre Guy Consolmagno (foto di Nicola Allegri)
-

-
Cecilia Rodriguez, foto di Novella 2000 di 27 maggio 2010
-

-
Roberto Allegri e Rodin (foto di Nicola Allegri)
-

-
Marni 2010
-

-
Egon Shiele eros
-

-
sogni erotici
-

-
Cristina davanti alla berlina
-

-
cane in vacanza
-

-

-
Il Cimitero delle Fontanelle di Napoli -Particolare-
-

-
L’entrata del Castello di Fumone
-

-
Particolare dell’altare della Chiesa del Purgatorio -Napoli-
-

-

-

-
Cagnolina Valentina
-

-
matrimonio
-

-
Aldo Sterchele
-

-
notte stellata van gogh
-

-

-

-
Le Vele di Girovoliamo
-

-
Belen Rodriguez
-

-
Copertina SANTE’ maggio 2007
-

-
Michelle Hunziker
-

-
Direttore Eliana Liotta (foto Paolo Liaci)
-

-
Joel Devillet
-

-
Stivali Mania
-

-
Silvestro Lega – Il pergolato1868
-

-
Lele Dinero
-

-
scimmia e cane
-

-
passerotto cip
-

-
violenza sessuale
-

-
Alessandro Marcucci Pinoli di Valfesina
-

-
Mark Rutte
-

-
Fedi-nuziali
-

-
Bela Lugosi
-

-
vampiri seconda parte
-

-
Sarah Scazzi
-

-
Rottweiler
-

-
vampiri
-

-

-

-

-
Congedo
-

-
candele a cuore
-

-
toto-cutugno-sanremo-2010
-

-
gesu_bambino
-

-
Rubens-gatta tricolore
-

-
rubens-citronella
-

-
rubens-fiamma
-

-
rubens-fiamma gatto
-

-
rubens in fiamme
-

-
dea bastet
-

-

-
capelli tagliati
-

-
Al Bano
-

-
albero-natale
-

-
Gino Santercole
-

-
Rubens e Peter
-

-
imma-africa
-

-
gatti e gravidanza
-

-

-
toxoplasmosi
-

-
gatti e gravidanza
-

-
fuochi d’artificio
-

-
voglia di vivere
-

-
torta-caprese
-

-
decoro caprese
-

-

-
Alfonso Signorini
-

-
pizza-salsicce-e-friarielli
-

-
friarielli
-

-
pizza salsicce e friarielli
-

-
Robert M.
-

-
minibus
-

-
volare
-

-
Il principe Diofebo VI Meli Lupi
-

-
tartaruga terrestre
-

-
tartaruga_terrestre-e-piccoli
-

-
terrario
-

-
tartaruga
-

-
Emanuela Z.
-

-
Vittorio Giannella
-

-
Acquario di Genova
-

-
Roberto Allegri
-

-
Cristina per Cofanetto
-

-
Andrea Bocelli
-

-
Flavio Briatore – Elisabetta Gregoraci
-

-
pipistrello
-

-
Graft – De Rijp
-

-

-
Il batterio Paenibacillus vortex
-

-
Stefano Biondo
-

-
marni
-

-
Monique Sluyter
-

-
Sartie borsone scarpe
-

-

-

-

-
chiacchiere di carnevale
-

-
chiacchiere con cioccolata
-

-
chiacchiere
-

-
chiacchiere con cioccolata 2
-

-
ciambelline
-

-
graffe-napoletane
-

-
passito-Pantelleria
-

-

-
Chiara Luce Badano
-

-
berny
-

-

-
berny 1
-

-

-
berny 2
-

-
berny 3
-

-
berny 4
-

-
Sanremo-2011-Gianni-Morandi
-

-
mimosa
-

-
mara venier
-

-
Bavette sul pesce
-

-
Ruggero Marino e Roberto Allegri
-

-
La scolaretta – Lorenzo Viani
-

-
ostaggi liberati
-

-

-
Valentina ancora dorme!
-

-
Come Valentina, anche gli altri membri della mia famiglia, dormono beatamente.
-

-
Peter
-

-
Rubens
-

-
cucciolo malinconico
-

-

-
manifesto
-

-
2-manifesto
-

-
gabbia
-

-
maltesino
-

-
cuccioli
-

-
nonno Lorenzo
-

-
Cristina editoriale
-

-

-
Mark Rutte
-

-
Meyer logo
-

-
Al Bano
-

-
Adriano Panatta
-

-
Joshua Bell
-

-
testimone Alphen aan de Rijn
-

-
Ing. Manola
-

-
vittima Alphen aan de Rijn
-

-

-

-

-
Scene da un matrimonio
-

-
tu prostituta
-

-
Papa Wojtyla
-

-
Amore e psiche di Antonio Canova
-

-
Lamberto Sposini
-

-
Ludmilla Radchenko
-

-
Donne sole
-

-
Compleanno
-

-
stella, meticcia di circa 14 anni trovata mentre vagava in autostrada
-

-
matisse
-

-
bella
-

-
lupen
-

-
Ulivi Puglia
-

-
Ylenia Carrisi
-

-
nina-en-pedofilia
-

-
neve ed i suoi 8 cuccioli
-

-
mamma neve
-

-

-
bulldog
-

-
mamma gatta
-

-
gattini da adottare
-

-
CrisBerry
-

-
casa-di-cioccolato
-

-
Cristina editoriale
-

-
Michela Fontana poesia foto 1
-

-
berny mare 2
-

-
berny mare
-

-

-
brook in lago
-

-
berny mare 3
-

-
brook in lago 2
-

-
Tiella
-

-
langos
-

-
salvatore-parolisi
-

-
Angela Marcella Guarnieri
-

-
01-Sardegna
-

-
cavia
-

-
Edoardo Raspelli
-

-
Madeleine McCann
-

-
viaggi donne sole
-

-
Matthew Lee
-

-
Wafel
-

-
Giulio Bonora
-

-
il piccolo cucciolo
-

-

-
mentre cerco di alimentarlo
-

-
il cucciolo oggi
-

-

-

-
gianna-nannini
-

-

-

-

-

-

-

-
Grace
-

-
Salvatore Parolisi
-

-
Lino Banfi
-

-
Gesù che predica
-

-
la ribollita
-
![bimba[1]](https://www.ilcofanettomagico.it/wp-content/uploads/bimba1-150x150.jpg)
-
![bimba_e_val[1]](https://www.ilcofanettomagico.it/wp-content/uploads/bimba_e_val1-150x150.jpg)
-
bimba_e_val[1]
-

-
bimba 3
-

-
citologico tumori
-

-

-
Claudio Foti
-

-
copertina eat parade
-

-
NATALE
-

-
L’Ambasciatore italiano in Olanda Franco Giordano
-

-
Cristina giornalista
-

-
Patty Pravo
-

-
Alluvione a Monterosso
-

-

-
Romina Power
-

-
Luna
-

-
Luna 2
-

-
Luna 3
-

-
Luna ed il suo padroncino
-

-
Torta al cioccolato con rose di crema al burro
-

-
truccare-il-viso-per-le-feste-di-natale
-

-
Rosanna Banfi
-

-
Ana Laura Ribas
-

-
Fiorello
-

-
Giorgio Napolitano
-

-
Roberto Vecchioni
-

-
buon natale 2011
-

-
coniglio
-

-
coniglio testa deviata
-

-
coniglio testa deviata 2
-

-

-
ariete
-

-
coniglio 2
-

-
mamma e fratellino di Erika
-

-
L’attesa, tempera su tela di Felice Casorati ( Novara 1883 – Torino 1963)
-

-
Modello strutturale e termico del satellite BepiColombo
-

-
Il Dottor Franco Ongaro
-

-
la pre-morte
-

-
buon anno
-

-
nave-costa-concordia-mentre-affonda
-

-
Sonia Peronaci
-

-
Venezia_Carnevale
-

-
maschera per editoriale
-

-
editoriale di San valentino
-

-
love
-

-

-

-
![clooney[1]](https://www.ilcofanettomagico.it/wp-content/uploads/clooney1-150x150.jpg)
-

-

-

-

-

-
uomo elefante
-

-
donne e soldi
-

-
maltrattamenti_casa_riposo
-

-
il miliardario e la fidanzata adottata
-

-

-

-
schettino
-

-
Oltre il confine – Gianfranco Iovino
-

-
Il principe Johan Friso e la moglie Mabel
-

-
2012 Sanremo – The 62nd Italian Song Festival – Closing Night
-

-
Castel del monte
-

-
Scoiattolo – Foto di Duco Das
-

-
Il mondo analizzato – foto di Hans Linsen
-

-
Matteo Zanni
-

-

-

-

-

-

-

-
melania-anello-fidanzamento
-

-
Giacomo Giannella, digital artist e ideatore del preogetto Streamcolors
-

-
Carlo Freccero, direttore di Rai 4
-

-
4155070297
-

-
Io ci credo – Al Bano – Roberto Allegri
-

-

-

-

-

-

-
Uova – Castello St Gerlach (Maastricht Olanda)
-

-
matteo zanni-mani
-

-
Nuvola
-

-
barzellette
-

-
incidente Svizzera
-

-
Lega Nord
-

-
yara-gambirasio
-

-
Piermario Morosini
-

-
Editoriale fiori
-

-
Brenda, caso Marrazzo
-

-
ragazzina partorisce
-

-

-

-

-

-

-

-
Umberto Eco
-

-
Editoriale giugno 2012
-

-
riflessione
-

-
van gogh x poesia
-

-
Angelo che invita al silenzio
-

-

-

-

-

-

-
Roberto Allegri
-

-
«Manto di vita» (copertina)
-

-
![2012-06-05-291[1]](https://www.ilcofanettomagico.it/wp-content/uploads/2012-06-05-2911-150x150.jpg)
-

-

-

-
Editoriale luglio 2012
-

-
Tartarughe
-

-
Editoriale agosto 2012
-

-
Francesco Baccini
-

-

-

-

-

-

-

-

-

-

-

-

-
Francesco Baccini
-

-
Nanni Moretti
-

-
Carla Regina
-

-
Corinaldo – Marche
-

-
Al Bano – maggio 2011
-

-
Editoriale settembre 2012 quaqua – 1
-

-
Editoriale ottobre 2012 quaqua
-

-
Erasmus MC Rotterdam
-

-
Radici
-

-
Albano Carrisi (Cellino San Marco – agosto 2012)
-
![geant_1[2]](https://www.ilcofanettomagico.it/wp-content/uploads/geant_12-150x150.jpg)
-

-

-

-

-

-

-
Samsom e Rutte
-

-
stemma_plisola
-

-
Maxima Medisch Centrum
-

-
Editoriale ottobre 2012 – Veluwezoom
-

-
Pietro Pancamo
-

-

-

-

-

-
foto 1 articolo suicidio
-

-
Den Haag
-

-
Caroline Tensen
-

-
Marilot moda
-

-
Editoriale novembre 2012
-

-
Valentino Di Persio e Al Bano
-

-
Sean Connors
-

-

-

-

-

-

-

-

-
babbo natale
-

-
buon natale 2012
-

-

-

-

-

-

-

-

-
Robbie-Williams
-

-

-

-

-
jose-pepe-mujica
-

-

-
Aldo Sterchele x Il Cofanetto Magico
-

-
Aldo Sterchele-150×150
-

-
Gemma Santinelli
-

-
Tim Ribberink
-

-
Aldo Sterchele, logo del Cofanetto Magico
-

-
Michelle Hunziker
-

-
Editoriale gennaio 2013 – Marie-Noelle Broug
-
![image[1]](https://www.ilcofanettomagico.it/wp-content/uploads/image1-150x150.jpg)
-

-

-
![image[1]](https://www.ilcofanettomagico.it/wp-content/uploads/image13-150x150.jpg)
-
![image[2]](https://www.ilcofanettomagico.it/wp-content/uploads/image2-150x150.jpg)
-
![image[2]](https://www.ilcofanettomagico.it/wp-content/uploads/image21-150x150.jpg)
-
![image[3]](https://www.ilcofanettomagico.it/wp-content/uploads/image3-150x150.jpg)
-
![image[4]](https://www.ilcofanettomagico.it/wp-content/uploads/image4-150x150.jpg)
-
![image[1]](https://www.ilcofanettomagico.it/wp-content/uploads/image14-150x150.jpg)
-
![image[3]](https://www.ilcofanettomagico.it/wp-content/uploads/image31-150x150.jpg)
-
![image[2]](https://www.ilcofanettomagico.it/wp-content/uploads/image22-150x150.jpg)
-

-

-

-

-

-

-

-

-

-

-
8 marzo festa della donna
-

-
Nel gorgo – Aldo Sterchele
-

-
Editoriale febbraio 2013
-

-
missoni – prima della partenza
-

-
da ridere, per cofanetto
-

-
amanti nel bistrot
-

-
La regina Beatrice
-

-
Papa_Benedetto_XVI
-

-
bomba atomica
-

-
Al Bano -Luciana Littizzetto
-

-

-

-

-

-

-
croce
-

-

-

-

-

-

-
Un particolare della pietà di Michelangelo
-

-
Jennifer Lopez
-

-
Editoriale aprile 2013
-

-

-

-
Oudenbosch basiliek
-

-
Yolanthe Cabau van Kasbergen
-

-
Kate Middleton e amica Jessica
-

-
Immortal
-

-
Palermo – cane
-

-
Fausto Nazer – Luci sotto la pioggia
-

-

-

-

-

-

-

-
roditori – degoe
-

-
Tutto procedeva a gonfie vele
-

-
Il nuovo re dei Paesi Bassi, Willem-Alexander e la regina Maxima il giorno dell’investitura
-

-
editoriale luglio polipo
-

-
Ristorante L’Accademia
-

-
Editoriale agosto 2013
-

-
Editoriale settembre – Alzheimer
-

-
Pupo – Cofanetto magico
-

-
Al Bano – 70 anni – DSC_1817
-

-
Secondo bigliettino Immortal
-

-
Little Tony – Maria Cristina Giongo
-

-

-

-

-

-

-

-

-

-

-

-

-

-

-
Frank Ferrante
-

-
il girasole poesia mio padre
-

-
A nudo per te – Sylvia Day
-

-
Priscilla – Cofanetto Magico
-

-
Sophia Loren
-

-
Al Bano
-

-

-
principe-johan-friso
-

-

-
Louise Vrolijk
-

-
Gabriele Elia
-

-
Cristina Giongo
-

-
Giovanni Allevi
-

-

-

-

-

-

-

-

-

-

-

-

-

-
Logo Carrisiland
-

-

-

-

-

-

-

-

-

-

-

-

-

-

-

-

-

-

-

-

-

-

-

-

-

-

-

-

-

-

-

-

-

-

-

-

-

-

-
Mauro Almaviva
-

-

-
Marica Caramia
-

-
Valentino Di Persio
-

-

-

-

-

-

-

-

-

-

-

-

-

-

-

-

-

-

-

-

-

-

-

-

-

-

-

-

-

-

-

-

-

-

-

-

-

-

-

-

-

-

-

-

-

-

-

-

-

-

-

-

-

-

-
Gabbie per cani
-

-

-

-

-

-

-

-

-

-

-

-

-

-

-

-

-

-

-

-

-

-

-

-

-

-

-

-

-

-

-

-

-

-

-

-

-

-

-

-

-

-

-

-

-

-

-

-

-

-

-

-

-

-

-

-

-

-

-

-

-

-

-

-

-

-

-

-

-

-

-

-

-

-

-

-
English Bulldog
-

-

-

-

-

-

-

-

-

-

-

-

-

-
16 week old Golden Retriever puppy scratching fleas with leg in motion on a white background “Missy”
-

-
16 week old Golden Retriever puppy scratching fleas with leg in motion on a white background “Missy”
-

-

-

-

-

-

-

-

-

-

-

-

-

-

-

-

-

-

-

-

-

-

-

-

-

-

-

-

-

-

-

-

-

-

-

-

-

-

-

-

-

-

-

-

-

-

-

-

-

-

-

-

-
Woman’s Back With Microscope And Magnifying Glass
-

-

-

-

-

-

-

-

-

-

-

-

-

-

-

-

-

-

-

-
Cute little girl hugging golden retriever with love eyes closed, smiling.
-

-

-

-

-

-

-

-

-

-

-

-

-

-

-

-

-

-

-

-

-

-

-

-

-

-

-

-

-

-

-

-

-

-

-

-

-

-

-

-

-

-

-

-

-

-

-

-

-

-

-

-

-

-

-

-

-

-

-

-

-

-

-

-

-

-

-

-

-

-

-

-

-

-

-

-

-

-

-

-

-

-

-

-

-

-

-

-

-

-

-

-

-

-

-

-

-

-

-

-

-

-

-

-

-

-

-

-

-

-

-

-

-

-

-

-

-

-

-

-

-

-

-

-

-

-

-

-

-

-

-

-

-

-

-

-

-

-

-

-

-

-

-

-
OLYMPUS DIGITAL CAMERA
-

-

-

-

-

-

-

-

-

-

-

-

-

-

-

-

-

-

-

-
dav
-

-
dig
-

-

-

-

-

-

-

-

-

-

-

-

-

-

-

-

-

-

-

-

-

-

-

-

-

-

-

-

-

-

-

-

-

-

-

-

-

-

-

-

-

-

-

-

-

-

-

-

-

-

-

-

-

-

-

-

-

-

-

-

-

-

-

-

-

-

-

-

-

-

-

-

-

-

-

-

-

-

-

-

-

-

-

-

-

-

-

-

-

-

-

-

-

-

-

-

-

-

-

-

-

-
Capside elicoidale. HE. E2/S = fusione. E1/M = matrice. E = (9-12 kD) N = nucleoproteina. HE = emagglutinina- esterasi. (solo in alcuni tipi) Malattie respiratorie (vie aeree superiori) – Gastroenteriti.
-

-

-

-

-

-

-

-

-

-

-

-

-

-

-

-
L’artista inglese Banksy ha voluto lasciare con una sua opera un personale tributo ai medici e agli infermieri del servizio sanitario britannico, il cosiddetto Nhs, impegnati nella lotta al coronavirus. Si tratta di un disegno, grande circa un metro quadrato, che è stato appeso vicino al pronto soccorso dell’ospedale di Southampton, Inghilterra meridionale, in accordo coi vertici dell’istituto. L’opera vede ritratto un bambino che gioca con alcuni supereroi e fra questi prende in mano un pupazzo con le sembianze di una infermiera e tanto di mascherina: questo a significare l’eroismo mostrato dal personale sanitario nella pandemia che ha sconvolto il Paese.
ANSA/BANKSY
-

-

-

-

-

-

-

-

-

-

-

-

-

-

-

-

-

-

-

-

-

-

-

-

-

-

-

-

-

-

-

-

-

-

-

-

-

-

-

-

-

-

-

-

-

-

-

-

-

-

-

-

-

-

-

-

-

-

-

-

-

-

-

-

-

-

-

-

-

-

-

-

-

-

-

-

-

-

-

-

-

-

-

-

-

-

-

-

-

-

-

-

-

-

-

-

-

-

-

-

-

-

-

-

-

-

-

-

-

-

-

-

-

-

-

-

-

-

-

-

-

-

-

-

-

-

-

-

-

-

-

-

-

-

-

-

-

-

-

-

-

-

-

-

-

-

-

-

-

-

-

-

-

-

-

-

-

-

-

-

-

-

-

-

-

-

-

-

-

-

-

-

-

-

-

-

-

Lascia un commento

![bimba[1]](https://www.ilcofanettomagico.it/wp-content/uploads/bimba1-150x150.jpg)
![bimba_e_val[1]](https://www.ilcofanettomagico.it/wp-content/uploads/bimba_e_val1-150x150.jpg)













































![clooney[1]](https://www.ilcofanettomagico.it/wp-content/uploads/clooney1-150x150.jpg)
































































![2012-06-05-291[1]](https://www.ilcofanettomagico.it/wp-content/uploads/2012-06-05-2911-150x150.jpg)



























![geant_1[2]](https://www.ilcofanettomagico.it/wp-content/uploads/geant_12-150x150.jpg)


















































![image[1]](https://www.ilcofanettomagico.it/wp-content/uploads/image1-150x150.jpg)


![image[1]](https://www.ilcofanettomagico.it/wp-content/uploads/image13-150x150.jpg)
![image[2]](https://www.ilcofanettomagico.it/wp-content/uploads/image2-150x150.jpg)
![image[2]](https://www.ilcofanettomagico.it/wp-content/uploads/image21-150x150.jpg)
![image[3]](https://www.ilcofanettomagico.it/wp-content/uploads/image3-150x150.jpg)
![image[4]](https://www.ilcofanettomagico.it/wp-content/uploads/image4-150x150.jpg)
![image[1]](https://www.ilcofanettomagico.it/wp-content/uploads/image14-150x150.jpg)
![image[3]](https://www.ilcofanettomagico.it/wp-content/uploads/image31-150x150.jpg)
![image[2]](https://www.ilcofanettomagico.it/wp-content/uploads/image22-150x150.jpg)






































































































































































































































































































































































































































































































































































































































































































































































































































